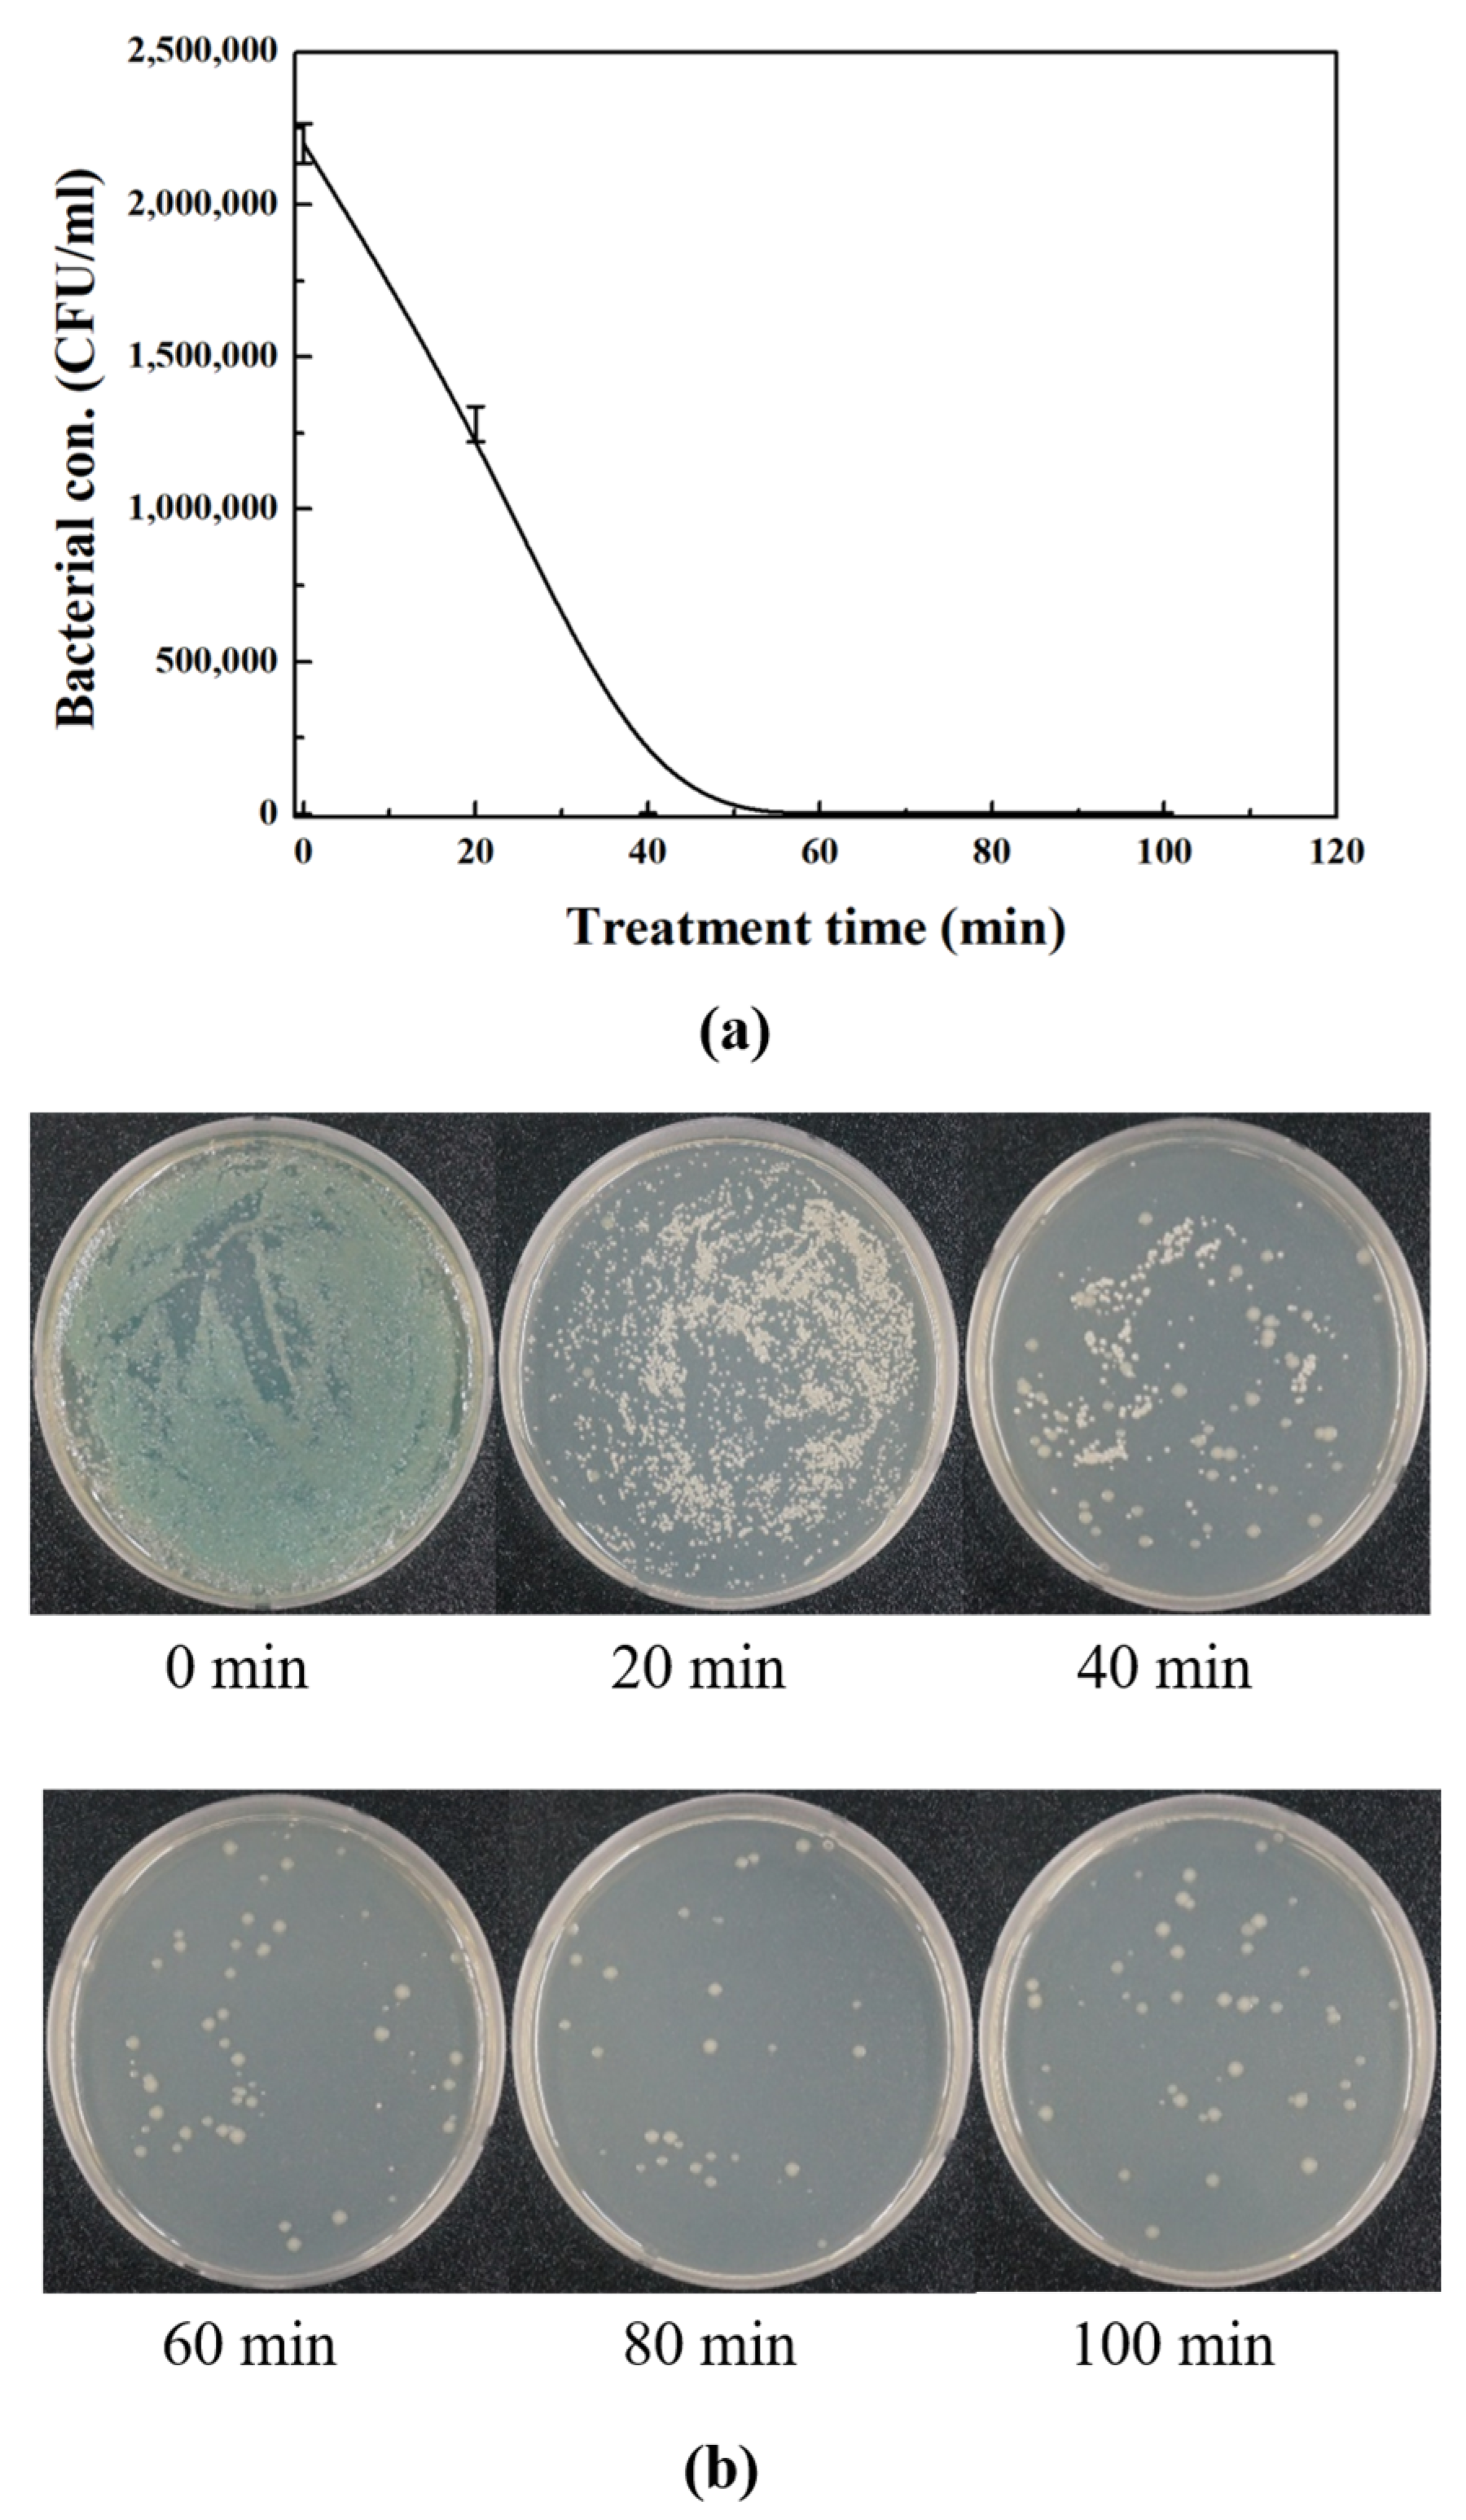
Applsci 13 12302 g006

Sterilization of Water-Based Cutting Fluids Using Compact Air-Cooled Coaxial Dielectric Barrier Discharge Reactor with Bubbler
Abstract
1. Introduction
2. Materials and Methods
2.1. Structure of Compact Air-Cooled Coaxial DBD Reactor with Bubbler
2.2. Analysis Equipment and Methods
2.3. Analysis of Bacteria
3. Results
3.1. Discharge of Compact Air-Cooled Coaxial DBD Plasma at Atmospheric Pressure
3.2. Analysis of Voltage and Current Waveform
3.3. Optical Emission Spectrum
3.4. Optimized Condition of Ozone Generation
3.5. Sterilization of Microorganism in Water-Soluble Cutting Fluids
3.6. Analysis of Water-Soluble Cutting Fluid Properties
4. Conclusions
Author Contributions
Funding
Informed Consent Statement
Data Availability Statement
Acknowledgments
Conflicts of Interest
References
- Yang, K.Z.; Pramanik, A.; Basak, A.K.; Dong, Y.; Prakash, C.; Shankar, S.; Dixit, S.; Kumar, K.; Vatin, N.I. Application of coolants during tool-based machining—A review. Ain Shams Eng. J. 2023, 14, 101830. [Google Scholar] [CrossRef]
- Mackerer, C.R. Health Effects of oil Mists: A Brief Review. Toxicol. Ind. Health 1989, 5, 429–440. [Google Scholar] [CrossRef] [PubMed]
- Wu, X.; Li, C.; Zhou, Z.; Nie, X.; Chen, Y.; Zhang, Y.; Cao, H.; Liu, B.; Zhang, N.; Said, Z.; et al. Circulating purification of cutting fluid: An overview. Int. J. Adv. Manuf. Technol. 2021, 117, 2565–2600. [Google Scholar] [CrossRef] [PubMed]
- Miyamoto, J.; Kodama, M.; Kawada, S.; Tsuboi, R. Tribiological Properties of Cutting Fluid Sterilizaed by Atmospheric-Pressure Plasma Treatment. Tribol. Online 2018, 13, 248–253. [Google Scholar] [CrossRef]
- Ma, S.; Kim, K.; Huh, J.; Kim, D.E.; Lee, S.; Hong, Y. Regeneration and purification of water-soluble cutting fluid through ozone treatment using an air dielectric barrier discharge. Sep. Purif. Technol. 2018, 199, 289–297. [Google Scholar] [CrossRef]
- Bakalova, S.; Doycheva, A.; Ivanova, I.; Groudeva, V.; Dimkov, R. Bacterial Microflora of Contaminated Metalworking Fluids. Biotechnol. Bioeng. 2014, 21, 37–441. [Google Scholar] [CrossRef]
- Li, K.; Aghazadeh, F.; Hatipkarasulu, S.; Ray, T.G. Health Risks From Exposure to Metal-Working Fluids in Machining and Grinding Operations. Int. J. Ind. Ergon. 2003, 9, 75–95. [Google Scholar] [CrossRef]
- Epelle, E.I.; Emmerson, A.; Nekrasova, M.; Macfarlane, A.; Cusack, M.; Burns, A.; Mackay, W.; Yassen, M. Microbial Inactivation: Gaseous or Aqueous Ozonation? Ind. Eng. Chem. Res. 2022, 61, 9600–9610. [Google Scholar] [CrossRef]
- Rosenblum, J.; Ge, C.; Bohrerova, Z.; Yousef, A.; Lee, J. Ozonation as a clean technology for fresh produce industry and environment: Sanitizer efficiency and wastewater quality. J. Microbiol. 2012, 113, 837–845. [Google Scholar] [CrossRef]
- Laroussi, M.; Mendis, D.A.; Rosenberg, M. Plasma interaction with microbes. New J. Phys. 2003, 5, 41. [Google Scholar] [CrossRef]
- Epelle, E.I.; Macfarlane, A.; Cusack, M.; Burns, A.; Okolie, J.A.; Mackay, W.; Rateb, M.; Yaseen, M. Ozone application in different industries: A review of recent developments. Chem. Eng. J. 2023, 454, 140188. [Google Scholar] [CrossRef]
- Gou, X.; Yuan, D.; Wang, L.; Xie, L.; Wei, L.; Zhang, G. Enhancing ozone production in dielectric barrier discharge utilizing water as electrode. Vaccum 2023, 212, 112047. [Google Scholar] [CrossRef]
- Al-Jobouri, H.H.; Ismaeel, H.O. Design an Ozone Generator by Using Dielectric Barrier Discharge. Al-Nahrain J. Sci. 2014, 17, 89–94. [Google Scholar]
- Kitayama, J.; Kuzumoto, M. Theoretical and experimental study on ozone generation characteristics of an oxygen-fed ozone generator in silent discharge. J. Phys. D Appl. Phys. 1997, 30, 2453. [Google Scholar] [CrossRef]
- Fang, Z.; Qiu, Y.; Sun, Y.; Wang, H.; Edmund, K. Experimental study on discharge characteristics and ozone generation of dielectric barrier discharge in a cylinder-cylinder reactor and a wire-cylinder reactor. J. Electrost. 2008, 66, 421–426. [Google Scholar] [CrossRef]
- Wang, C.; Zhang, G.; Wang, X.; He, X. The effect of air plasma on barrier dielectric surface in dielectric barrier discharge. Appl. Surf. Sci. 2010, 257, 1698–1702. [Google Scholar] [CrossRef]
- EzBioCloud. Available online: https://www.ezbiocloud.net (accessed on 15 May 2023).
- Benard, N.; Moreau, E. Electrical and mechanical characteristics of surface AC dielectric barrier discharge plasma actuators applied to airflow control. Exp. Fluids 2014, 55, 1846. [Google Scholar] [CrossRef]
- Borghi, C.A.; Cristofolini, A.; Grandi, G.; Neretti, G.; Seri, P. A plasma aerodynamic actuator supplied by a multilevel generator operating with different voltage waveforms. Plasma Sources Sci. Technol. 2015, 24, 045018. [Google Scholar] [CrossRef]
- Rajasekaran, P.; Mertmann, P.; Bibinov, N.; Wandke, D.; Viol, W.; Awakowicz, P. DBD plasma source operated in single-filamentary mode for therapeutic use in dermatology. J. Phys. D Appl. Phys. 2009, 42, 225201. [Google Scholar] [CrossRef]
- Ma, S.; Lee, S.; Kim, K.; Im, J.; Jeon, H. Purification of organic pollutants in cationic thiazine and azo dye solutions using plasma-based advanced oxidation process via submerged multi-hole dielectric barrier discharge. Sep. Purif. Technol. 2021, 255, 117715. [Google Scholar] [CrossRef]
- Kefeng, S.; Meiwei, W.; Bangfa, P.; Jie, L.; Na, L.; Nan, J.; Yan, W. Characterization of a novel volume-surface DBD reactor: Discharge characteristics, ozone production and benzene degradation. J. Phys. D Appl. Phys. 2020, 53, 065201. [Google Scholar]
- Yu, S.; Chen, Q.; Liu, J.; Wang, K.; Jiang, Z.; Sun, Z.; Zhang, J.; Fang, J. Dielectric barrier structure with hollow electrodes and its recoil effect. Appl. Phys. Lett. 2015, 106, 244101. [Google Scholar] [CrossRef]
- Dave, H.; Ledwani, L.; Chandwani, N.; Kikani, P.; Desai, B.; Chowdhuri, M.B.; Nema, S.K. Use of dielectric barrier discharge in air for surface modification of polyester substrate to confer durable wettability and enhance dye uptake with natural dye eco-alizarin. Compos. Interface 2012, 19, 219–229. [Google Scholar] [CrossRef]
- Batakliev, T.; Georgiev, V.; Anachkov, M.; Rakovsky, S.; Zaikov, G.E. Ozone decomposition. Interdiscip. Toxicol. 2014, 7, 47–59. [Google Scholar] [CrossRef]
- Amoureux, L.; Bador, J.; Fardeheb, S.; Mabille, C.; Couchot, C.; Massip, C.; Salignon, A.-L.; Berkuem, G.; Varubm, V.; Neuwirth, C. Detection of Achromobacter xylosoxidans in Hospital, Domestic, and Outdoor Environmental Samples and Comparison with Human Clinical Isolates. J. Appl. Envrion. Microbiol. 2013, 79, 7142–7149. [Google Scholar] [CrossRef]
- Ye, L.; Guo, M.; Ren, P.; Wang, G.; Bian, Y.; Xiao, Y.; Zhou, Y. First report of a cross-kingdom pathogenic bacterium, Achromobacter xylosoxidans isolated from stipe-rot Coprinus comatus. Microbiol. Res. 2018, 207, 249–255. [Google Scholar] [CrossRef]
- Ahamed Basha, K.; Joseph, T.C.; Lalitha, K.V.; Vineetha, D.; Rathore, G.; Tripati, G.; Pani Prasad, K. Nitrification Potential of Achromobacter xylosoxidans Isolated from Fresh Water Finfish Farms of Kerela, India. Int. J. Curr. Microbiol. 2018, 7, 2645–2654. [Google Scholar]
- Xu, Y.-Y.; Lu, H.; Wang, X.; Zhang, K.-Q.; Li, G.-H. Effect of Volatile Organic Compounds from Bacteria on Nematodes. Chem. Biodivers. 2015, 12, 1415–1421. [Google Scholar] [CrossRef]
- Mohamdpoor, M.; Amini, J.; Ashengroph, M.; Azizi, A. Evaluation of biocontrol potential of Achromobacter xylosoxidans strain CTA8689 against common bean root rot. Physiol. Mol. Plant Pathol. 2022, 117, 101769. [Google Scholar] [CrossRef]
- Jung, W.J.; Kim, H.J.; Giri, S.S.; Kim, S.G.; Kim, S.W.; Kang, J.W.; Kwon, J.; Lee, S.B.; Oh, W.T.; Jun, J.W.; et al. Citrobacter tructae sp. nov. Isolated from Kidney of Diseased Rainbow Trout (Oncorhynchus mykiss). Microorganisms 2021, 9, 275. [Google Scholar] [CrossRef]
- Tan, C.-K.; Lai, C.-C.; Lin, S.-H.; Liao, C.-H.; Huang, Y.-T.; Hsueh, P.-R. Fatal Citrobacter farmer Meningitis in a Patient with Nasopharyngeal Cancer. J. Clin. Microbiol. 2010, 48, 1499–1500. [Google Scholar] [CrossRef] [PubMed][Green Version]
- Ren, Y.; Peng, L.-H.; Deng, L.-J.; Wei, C.-H. Isolation and Characterization of Citrobacter farmer SC01: A Novel m-Cresol-Degrading Strain. Environ. Eng. Sci. 2009, 26, 1489–1495. [Google Scholar] [CrossRef]
- de Bentzmann, S.; Plésiat, P. The Pseudomonas aeruginosa opportunistic pathogen and human infections. Environ. Microbiol. 2011, 13, 1655–1665. [Google Scholar] [CrossRef] [PubMed]
- Gad, G.F.; El-Domany, R.A.; Zaki, S.; Ashour, H.M. Characterization of Pseudomonas aeruginosa isolated from clinical and environmental samples in Minia, Egypt: Prevalence, antibiogram and resistance mechanisms. J. Antimicrob. Chemother. 2007, 60, 1010–1017. [Google Scholar] [CrossRef]
- Li, Y.; Cui, T.; Wang, Y.; Ge, X. Isolation and characterization of a novel bacterium Pseudomonas aeruginosa for biofertilizer production from kitchen waste oil. RSC Adv. 2018, 8, 41966–41975. [Google Scholar] [CrossRef]
- Filipiak, W.; Sponring, A.; Baur, M.M.; Filipiak, A.; Ager, C.; Wiesenhofer, H.; Nagl, M.; Troppmair, J.; Amann, A. Molecular analysis of volatile metabolites released specifically by Staphylococcus aureus and Pseudomonas aeruginosa. BMC Microbiol. 2012, 12, 113. [Google Scholar] [CrossRef]
- Fujiki, Y.; Mato, N.; Watanabe, S.; Shibano, T.; Tonai, K.; Takahashi, K.; Satio, T.; Okuyama, A.; Takigami, A.; Bando, M.; et al. Virulent Pseudomonas aeruginosa pneumonia in an immunocompetent adult associated with a home whirlpool bath: A case report. Respir. Med. Case Rep. 2022, 38, 101673. [Google Scholar] [CrossRef]
- Khan, N.H.; Ishii, Y.; Kimata-Kino, N.; Esaki, H.; Nishino, T.; Nishimura, M.; Kogure, K. Isolation of Psudomonas aeruginosa from Open Ocean and Comparison with Freshwater, Clinical, and Animal Isolates. Microb. Ecol. 2007, 53, 173–186. [Google Scholar] [CrossRef]
- Tao, Y.; Zhou, Y.; He, X.; Hu, X.; Li, D. Pseudomonas chengduensis sp. nov., isolated from ladnfill leachate. Int. J. Syst. Evol. Microbiol. 2014, 64, 95–100. [Google Scholar] [CrossRef]
- Arikan, K.; Aykan, H.H.; Kara, A.; Cengiz, A. Pseudomonas oleovorans Endocarditis ina Child: The First Reported Case. J. Pediatr. Inf. 2018, 12, 3115–3117. [Google Scholar] [CrossRef]
- Sheoran, N.; Nadakkakath, A.V.; Munjal, V.; Kundu, A.; Subaharan, K.; Venugopla, V.; Rajamma, S.; Eapen, S.J.; Kumar, A. Genetic analysis of plant endophytic Pseudomonas putida BP25 and chemo-profiling of its antimicrobial volatile organic compounds. Microbiol. Res. 2015, 173, 66–78. [Google Scholar] [CrossRef] [PubMed]
- Gautam, L.; Kaur, R.; Kumar, S.; Bansal, A.; Gautam, V.; Singh, M.; Ray, P. Pseudomonas oleovorans Sepsis in a Child: The First Reported Case in India. Jpn. J. Infect. Dis. 2015, 68, 254–255. [Google Scholar] [CrossRef]
- Xu, J.; Qiu, X.; Dai, J.; Cao, H.; Yang, M.; Zhang, J.; Xu, M. Isolation and Characterization of a Pseudomonas oleovorans Degrading the Chloroacetamide Herbicide Acetochlor. Biodegradation 2006, 17, 219–225. [Google Scholar] [CrossRef] [PubMed]
- Milanowski, M.; Monedeiro, F.; Złoch, M.; Ratiu, I.-A.; Pomastowski, P.; Ligor, T.; de Martinis, B.S.; Buszewski, B. Profiling of VOCs released from different salivary bacteria treated with non-lethal concentrations of silver nitrate. Anal. Biochem. 2019, 578, 36–44. [Google Scholar] [CrossRef]
- Berkhout, D.J.C.; van Keulen, B.J.; Niemarkt, H.J.; Bessem, J.R.; de Boode, W.P.; Cossey, V.; Hoogenes, N.; Hulzebos, C.V.; Klaver, E.; Andriessen, P.; et al. Late-onset Sepsis in Preterm Infants Can Be Detected Preclinically by Fecal Volatile Organic Compound Analysis: A Prospective, Multicenter Cohourt Study. Clin. Infect. Dis. 2019, 68, 70–77. [Google Scholar] [CrossRef] [PubMed]
- Liu, C.; Zhao, X.; Xie, H.; Zhang, X.; Li, K.; Ma, C.; Fu, Q. Whole genome sequence and comparative genome analyses of multi-resistant Staphylococcus warneri GD01 isolated from a diseased pig in China. PLoS ONE 2020, 15, e0233363. [Google Scholar]
- Campoccia, D.; Montanaro, L.; Visai, L.; Corazzari, T.; Poggio, C.; Pegreffi, F.; Maso, A.; Pirini, V.; Ravaioli, S.; Cangini, I.; et al. Characterization of 26 Staphylococcus warneri isolates from orthopaedic infections. Int. J. Artif. Organs 2010, 33, 575–581. [Google Scholar] [CrossRef]
- Xue, W.; Macleod, J.; Blaxland, J. The use of ozone technology to control microorganism growth, enhance food safety and extend shelf life: A promising food decontamination technology. Foods 2023, 12, 814. [Google Scholar] [CrossRef]
- Reddy, S.V.R.; Rao, D.V.S.; Sharma, R.R.; Preethi, P.; Pandiselvanm, R. Role of ozone in post-harvest disinfection and processing of horticultural crops: A review. Ozone Sci. Eng. 2022, 44, 127–146. [Google Scholar] [CrossRef]

| Species No. | Species Name | Properties | Reference | ||
|---|---|---|---|---|---|
| Location | Odor | Human Infection | |||
| A | Achromobacter xylosoxidans | Human, environment | ○ | ○ | [26,27,28,29,30] |
| B | Citrobacter farmeri | Human, environment | ○ | ○ | [31,32,33] |
| C | Pseudomonas aeruginosa | Human, animal, environment | ○ | ○ | [34,35,36,37,38,39,40] |
| D | P. chengduensis | Landfill leachate | ○ | X | [41] |
| E | P. oleovorans | Human, environment | ○ | ○ | [42,43,44] |
| F | Staphylococcus warneri | Human, animal | ○ | ○ | [45,46,47,48] |
Disclaimer/Publisher’s Note: The statements, opinions and data contained in all publications are solely those of the individual author(s) and contributor(s) and not of MDPI and/or the editor(s). MDPI and/or the editor(s) disclaim responsibility for any injury to people or property resulting from any ideas, methods, instructions or products referred to in the content. |
© 2023 by the authors. Licensee MDPI, Basel, Switzerland. This article is an open access article distributed under the terms and conditions of the Creative Commons Attribution (CC BY) license (https://creativecommons.org/licenses/by/4.0/).
Share and Cite
Chun, S.M.; Ahn, G.R.; Yang, G.W.; Lee, H.J.; Hong, Y.C. Sterilization of Water-Based Cutting Fluids Using Compact Air-Cooled Coaxial Dielectric Barrier Discharge Reactor with Bubbler. Appl. Sci. 2023, 13, 12302. https://doi.org/10.3390/app132212302
Chun SM, Ahn GR, Yang GW, Lee HJ, Hong YC. Sterilization of Water-Based Cutting Fluids Using Compact Air-Cooled Coaxial Dielectric Barrier Discharge Reactor with Bubbler. Applied Sciences. 2023; 13(22):12302. https://doi.org/10.3390/app132212302
Chicago/Turabian StyleChun, Se Min, Geum Ran Ahn, Geon Woo Yang, Hee Jae Lee, and Yong Cheol Hong. 2023. "Sterilization of Water-Based Cutting Fluids Using Compact Air-Cooled Coaxial Dielectric Barrier Discharge Reactor with Bubbler" Applied Sciences 13, no. 22: 12302. https://doi.org/10.3390/app132212302
APA StyleChun, S. M., Ahn, G. R., Yang, G. W., Lee, H. J., & Hong, Y. C. (2023). Sterilization of Water-Based Cutting Fluids Using Compact Air-Cooled Coaxial Dielectric Barrier Discharge Reactor with Bubbler. Applied Sciences, 13(22), 12302. https://doi.org/10.3390/app132212302

